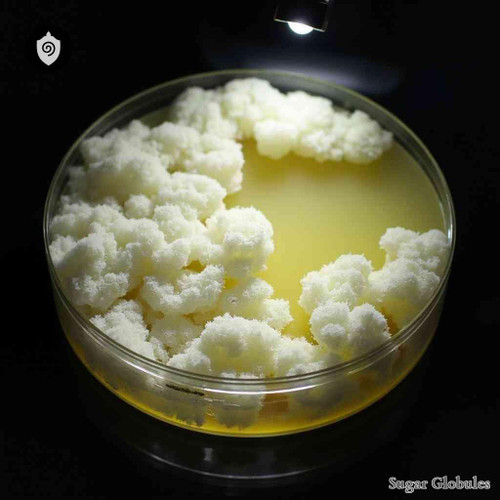
Streptomyces Albus sugar spheres in consistent pellet form for energetic homeopathic (nonmedical) dry-form product presentation

Origin - Soil-derived Actinomycete
Chemical Profile - Polyketides, Aminoglycosides
Classification - Actinobacteria
Use - Recognized in energetic homeopathic (nonmedical) practices
Description:
Streptomyces noursei, a soil-derived Actinomycete classified under Actinobacteria, is noted for its complex polyketide and aminoglycoside compounds. Its molecular diversity has been a focus in both natural product chemistry and biotechnological studies, highlighting its significance in microbial research. Known for its phytochemical diversity. Inspect similar product - Tune In to the Biofield Energy Relay.
Chemical Profile - Polyketides, Aminoglycosides
Classification - Actinobacteria
Use - Recognized in energetic homeopathic (nonmedical) practices
Description:
Streptomyces noursei, a soil-derived Actinomycete classified under Actinobacteria, is noted for its complex polyketide and aminoglycoside compounds. Its molecular diversity has been a focus in both natural product chemistry and biotechnological studies, highlighting its significance in microbial research. Known for its phytochemical diversity. Inspect similar product - Tune In to the Biofield Energy Relay.